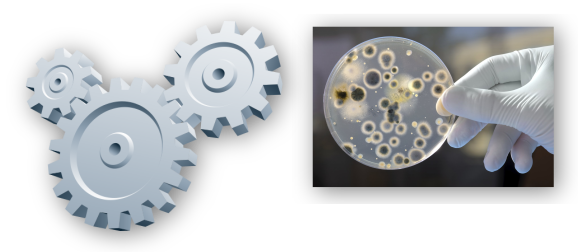

A Higienização na Indústria Alimentícia
Entende-se por Higienização, todas as tarefas e controles que se fazem necessários para assegurar que o leite, carne, bebidas e seus derivados, cheguem ao consumidor em condições apropriadas para o consumo, mantendo o seu valor nutritivo
e principalmente eliminando os micro-organismos que possam causar danos à saúde, (Patogênicos).
Para tal se faz necessário:
- Local de trabalho adequado
- Equipamentos e utensílios sanitário
- Higiene pessoal e manutenção adequada do alimento
- Limpeza e desinfecção eficientes.